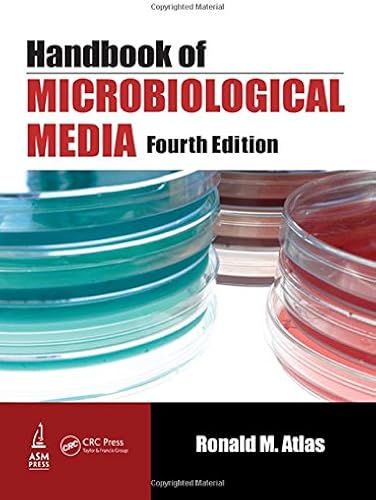

[Télécharger] Handbook of Microbiological Media, Fourth Edition de Ronald M. Atlas Pdf Epub
Télécharger Handbook of Microbiological Media, Fourth Edition de Ronald M. Atlas livre En ligne
Télécharger "Handbook of Microbiological Media, Fourth Edition" de Ronald M. Atlas Francais PDF
Auteur : Ronald M. Atlas
Catégorie : Livres anglais et étrangers,Science,Agricultural Sciences
Broché : * pages
Éditeur : *
Langue : Français, Anglais
Handbook of Microbiological Media, Fourth Edition is an invaluable reference for every medical, veterinary, diagnostic, and academic laboratory, and now in its fourth edition, it is even more complete. This edition carries on the tradition of CRC Press handbook excellence, listing the formulations, methods of preparation, and uses for more than 7,000 microbiological media. With 1,500 more entries than any previous edition, the handbook includes both classic and modern media used for the identification, cultivation, and maintenance of diverse bacteria, archaea, and fungi. The breadth of culture media in this comprehensive resource is enormous and has greatly expanded in recent years with the exploration of extreme habitats and the use of molecular methods to identify new lineages of bacteria and archaea. The media also represent significant advances in the ability to use chromogenic substrates to identify specific species and strains of bacteria, e.g., E. coli O157 and methicillin-resistant Staphylococcus aureus (MRSA). These media are extremely useful for clinical diagnostics and for the protection of the food supply from pathogenic microorganisms. With over 7,000 formulations, this new edition includes all the media used for: Routine examination of food and water Cultivating specific strains of bacteria, archaea, fungi, and protists, including many anaerobes and extremophiles Cultivating the numerous microorganisms currently available from the world’s global bioresource centers (BRCs) Additionally, many culture media are now available that are free of animal components. Plant-based media eliminate possible contamination with prions, which is important for production of vaccines and pharmaceuticals. The entries are arranged alphabetically by medium name and include composition, instructions for preparation, commercial sources, safety cautions, uses, and more. This reference contains the most comprehensive compilation of microbiological media available in a single volume. The only resource you need for all media types, it makes finding media for culturing diverse microorganisms quick and simple. With uniform presentations of media formulations and preparations, it presents easy-to-follow directions and cookbook recipes for preparing media. You won’t find a more complete or user-friendly microbiology reference anywhere.
Télécharger Handbook of Microbiological Media, Fourth Edition de Ronald M. Atlas Livres En Ligne
Handbook of Microbiological Media 4th Edition PDF ~ The fourth edition of the Handbook of Microbiological Media includes the media needed to cultivate the numerous microorganisms currently available from the world’s global bioresource centers (BRCs). The breadth of culture media in this comprehensive resource is enormous and has greatly expanded in recent years with the exploration of extreme habitats and the use of molecular methods to .
Handbook of Microbiological Media (English Edition) eBook ~ Achetez et téléchargez ebook Handbook of Microbiological Media (English Edition): Boutique Kindle - Infectious Disease : Amazon
Handbook of Microbiological Media, Fourth Edition - Ronald ~ Handbook of Microbiological Media, Fourth Edition is an invaluable reference for every medical, veterinary, diagnostic, and academic laboratory, and now in its fourth edition, it is even more complete. This edition carries on the tradition of CRC Press handbook excellence, listing the formulations, methods of preparation, and uses for more than 7,000 microbiological media.
Handbook of Microbiological Media - Routledge Handbooks ~ Handbook of Microbiological Media, Fourth Edition is an invaluable reference for every medical, veterinary, diagnostic, and academic laboratory, and now in its fourth edition, it is even more complete. This edition carries on the tradition of CRC Press handbook excellence, listing the formulations, methods of preparation, and uses for more than 7,000 microbiological media.
Handbook of Microbiological Media - relié - Achat Livre / fnac ~ Handbook of Microbiological Media. Des milliers de livres avec la livraison chez vous en 1 jour ou en magasin avec -5% de réduction .
Handbook of Microbiological Media / Taylor & Francis Group ~ Handbook of Microbiological Media, Fourth Edition is an invaluable reference for every medical, veterinary, diagnostic, and academic laboratory, and now in its fourth edition, it is even more complete. This edition carries on the tradition of CRC Press handbook excellence, listing the formulations, methods of preparation, and uses for more tha
9781439804063: Handbook of Microbiological Media, Fourth ~ Handbook of Microbiological Media, Fourth Edition is an invaluable reference for every medical, veterinary, diagnostic, and academic laboratory, and now in its fourth edition, it is even more complete. This edition carries on the tradition of CRC Press handbook excellence, listing the formulations, methods of preparation, and uses for more than 7,000 microbiological media.
Télécharger des livres de Microbiologie for free - PDF ~ Téléchargez les livres de microbiologie et de biochimie au format PDF. La bibliothèque BioEduc comprend des livres électronique PDF téléchargeables gratuitement et des exercices corrigés pour les étudiants en biologie et en médecine.
Livre practical handbook of microbiology - immunologie ~ Providing basic knowledge and practical information on working with microorganisms, Practical Handbook of Microbiology, Second Edition is designed to facilitate highly specialized working microbiologists, as well as those who simply use microbiology as an adjunct to their own discipline, in finding relevant information easily, in a clear and concise single volume
Electronic library. Download books free. Finding books ~ Electronic library. Download books free. Finding books / Z-Library. Download books for free. Find books
Télécharger des livres de Microbiologie en PDF / BioEduc ~ Télécharger des livres de Microbiologie en PDF Handbook of Media for Environmental Microbiology Biotechnology Applying the Genetic Revolution Biochimie Clinique
Amazon - The Handbook of Microbiological Media for the ~ Noté /5. Retrouvez The Handbook of Microbiological Media for the Examination of Food et des millions de livres en stock sur Amazon. Achetez neuf ou d'occasion
Handbook of Microbiological Media, Fourth Edition (Anglais ~ Noté /5. Retrouvez Handbook of Microbiological Media, Fourth Edition et des millions de livres en stock sur Amazon. Achetez neuf ou d'occasion
Handbook of Microbiological Media, Fourth Edition: Amazon ~ Handbook of Microbiological Media, Fourth Edition: Amazon: Ronald M. Atlas: Libros en idiomas extranjeros
- Download PDF Files / Pdf download, Pdf, Download ~ Jan 30, 2016 - Best and safely free ebooks and pdf files download
Microbiologie - bactériologie ~ Livre + DVD. Numéro de revue ">Sécurité alimentaire / h. Sucre et produits sucrés . Télécharger 45,00 € Manuel de poche de microbiologie médicale Coll. Atlas de poche. Auteurs : KAYSER Fritz, BÖTTGER Erik C., DEPLAZES Peter, HALLER Otto, ROERS Axel. Langue : Français. 11-2016 — 741 p. — 12.7x19 cm — Quadrichromie. ISBN : 9782257206367 — Médecine Sciences SIDA .
Handbook of Microbiological Media, 3rd ed. / Sigma-Aldrich ~ The third edition lists the formulations, methods of preparation, and uses for more than 4,000 microbiological media. With almost 30 percent more entries than the previous edition, the book includes new information on international collections of microorganisms. It also contains formulations and uses of media for isolation, culture, identification, and maintenance of microorganisms. The .
Télécharger Microbiologie alimentaire PDF Livre ~ Télécharger Microbiologie alimentaire PDF Livre Cet ouvrage fait la synthèse en 187 fiches des nombreux domaines abordés par la chimie générale (thermodynamique; atomistique; cinétique des réactions; liaisons chimiques…). Quelques fiches présentent les techniques d’analyse courantes : RMN; fluorescence X; chromatographie .
Télécharger des livres de Microbiologie for free - PDF ~ 11 mai 2019 - Télécharger des livres de Microbiologie pdf Click to download Click to download Click to download Click to download Livres microbiologie pour les analy…
Handbook of Microbiological Media, Fourth Edition free ~ Apr 5, 2016 - Download free Handbook of Microbiological Media Fourth Edition pdf
Livres sur Google Play ~ Profitez de millions d'applications Android récentes, de jeux, de titres musicaux, de films, de séries, de livres, de magazines, et plus encore. À tout moment, où que vous soyez, sur tous vos appareils.
Livres PDF - Home / Facebook ~ Livres PDF. 3.8K likes. Livres PDF telecharger gratuit. Télécharger Le Temps des Tempêtes PDF. Télécharger Le Temps des Tempêtes EPUB, PDF Gratuitement, Télécharger Le Temps des Tempêtes PDF vos Ebook Gratuit français Gratuitement en format Epub, PDF, Kindle et utiliser votre lisseuse préférée pour les lire.
Télécharger PDF Microbiologie alimentaire (French Edition) ~ Facile, vous seulement Klick Télécharger PDF lien de téléchargement Microbiologie alimentaire (French Edition) livre sur ces pages et vous sera dirigé vers le formulaire d’inscription gratuite. après le inscription gratuite vous auront un moyen pour télécharger le livre en format 4. PDF au format 8,5 x toutes les pages, EPub reformaté spécifiquement pour réserver lecteurs, Mobi .
Microbiologie 5éme édition - Fnac Livre ~ Pour écouter votre livre audio, télécharger l'application KOBO BY FNAC sur Play store et sur Appstore. Puis connectez-vous avec votre compte fnac. Et lancez l'écoute ! Résumé ; Conseils Fnac; Avis clients; Caractéristiques; Microbiologie Résumé La "Microbiologie de Prescott", traduction de la 10e édition d'un classique de la Microbiologie, le « Prescott's Microbiology », est un gra
MediaWiki/fr - MediaWiki ~ Le logiciel MediaWiki est utilisé par des dizaines de milliers de sites web et des milliers de sociétés et d’organisations.C’est sur lui que reposent Wikipédia et ce site web. MediaWiki vous aide à recueillir et organiser les connaissances et à les rendre accessibles aux autres.
Comments
Post a Comment